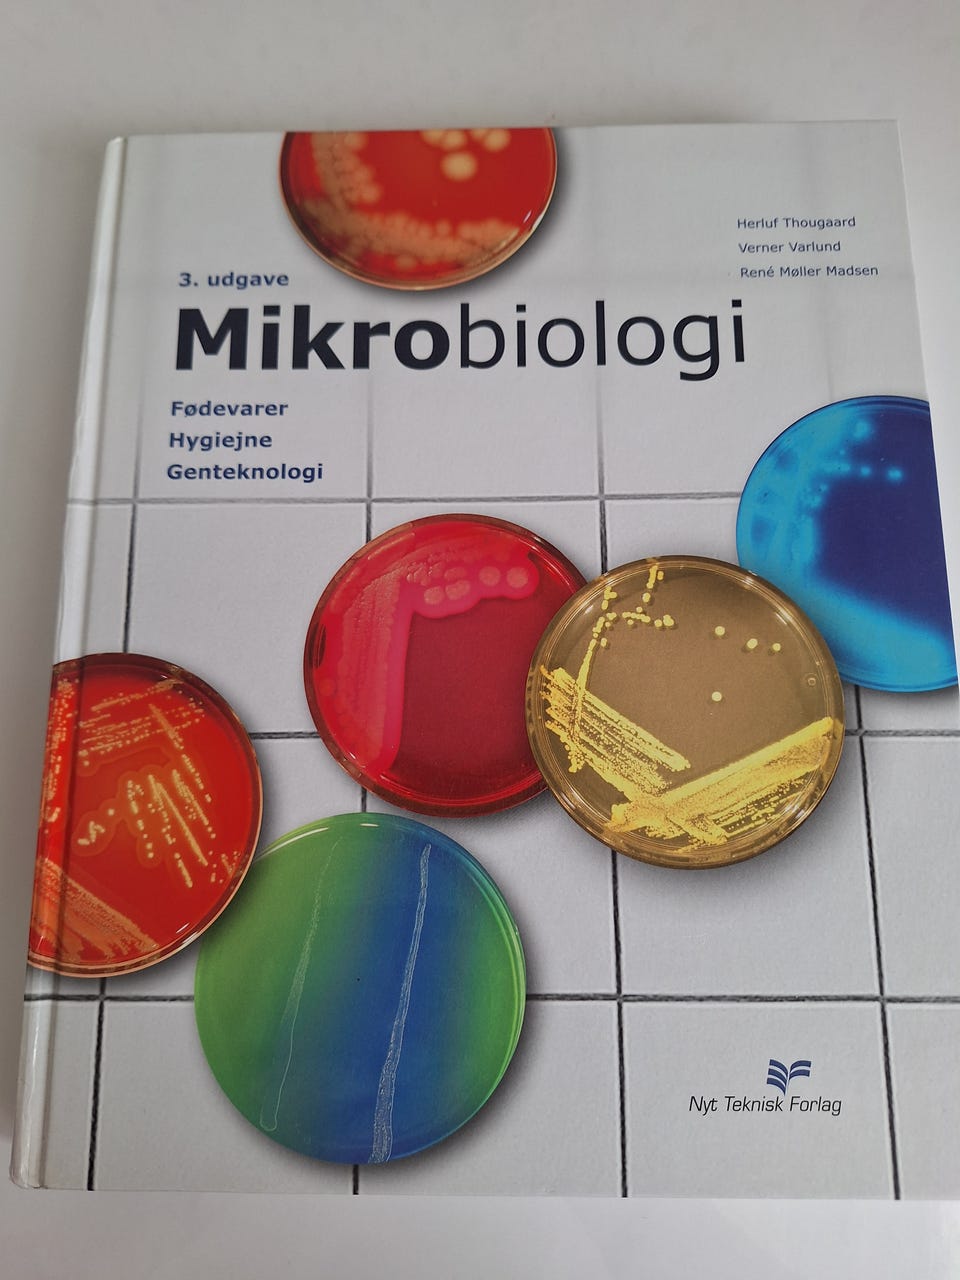
Galleribillede
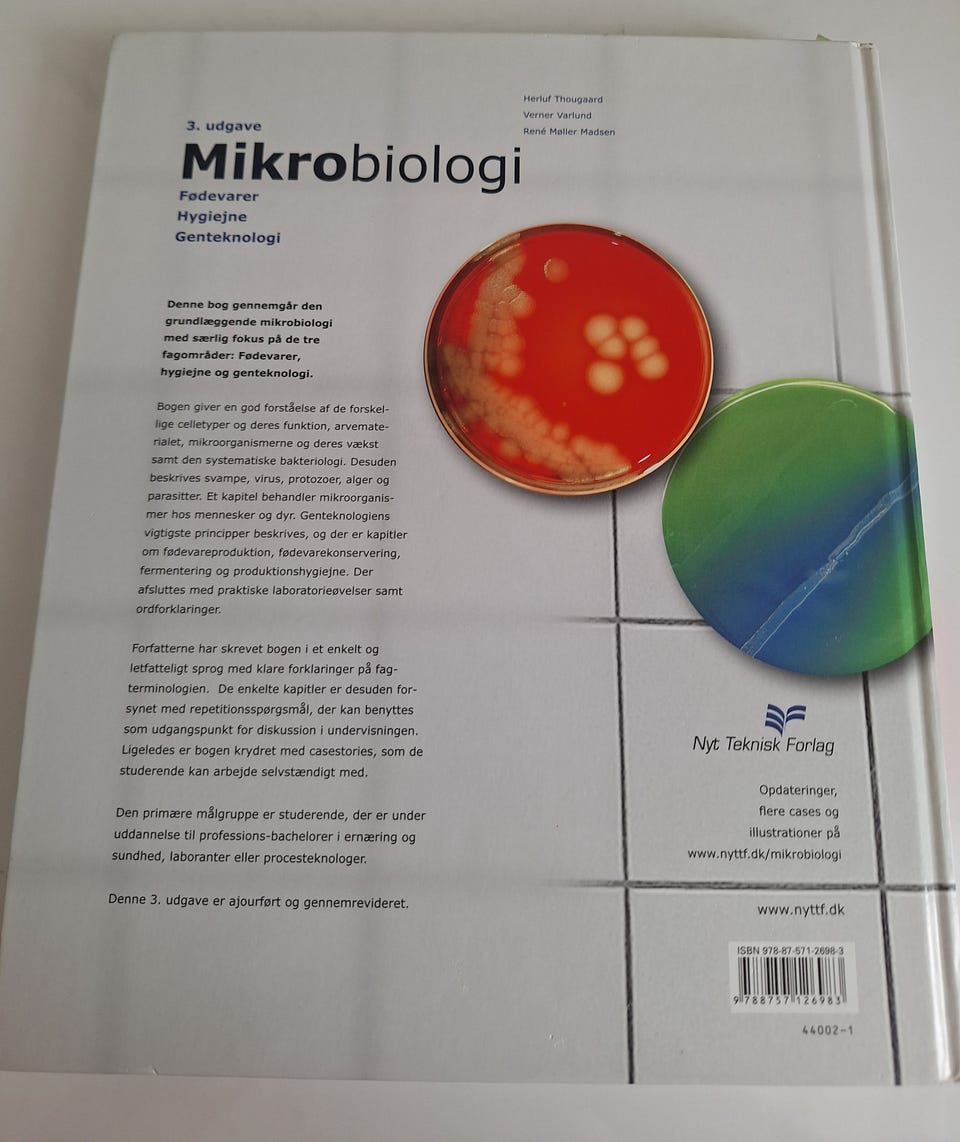
Galleribillede

Billedgalleri
Nyt Teknisk Forlag Mikrobiologi lærebog biologi
Til salg
Fragt fra 29,99 kr. + Tryg betaling 16 kr.
Tryg handel med Fiks færdig
Fiks færdig er DBA's nye betalings- og fragttjeneste. Efter levering har du 24 timer til at kontrollere varen, før pengene udbetales til sælgeren.
Varebeskrivelse
Stand: Som ny - ingen synlige brugsspor
Emne: Biologi
Nyt Teknisk Forlag Mikrobiologi lærebog i biologi. Bogen er 3. udgave, 1. oplag 2009 og omhandler mikrobiologi med fokus på fødevarer, hygiejne og genteknologi. Teksten er på dansk og er velegnet som fagbog til undervisning eller som opslagsværk inden for biologiske og mikrobiologiske emner. Hardback-udgave med faglig gennemgang af mikroorganismer, hygiejneprincipper og anvendt genteknologi.
Brugerprofil

Du skal være logget ind for at se brugerprofiler og sende beskeder.
Log indAnnoncens metadata
Sidst redigeret: 28.2.2026 kl. 07:02 ・ Annonce-ID: 19059728